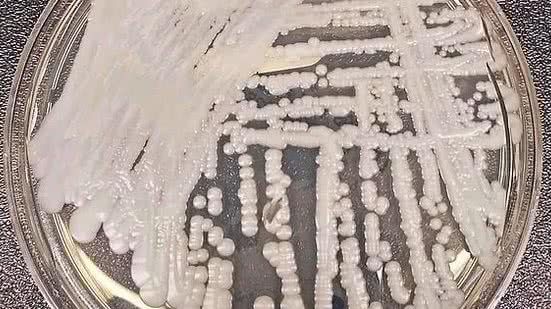

Em maio do ano passado, um homem idoso foi admitido no Hospital Mount Sinai no Brooklyn para uma cirurgia abdominal. Um exame de sangue revelou que ele havia sido infectado por um germe letal e misterioso, descoberto há pouco tempo.
Em maio do ano passado, um homem idoso foi admitido no Hospital Mount Sinai no Brooklyn para uma cirurgia abdominal. Um exame de sangue revelou que ele havia sido infectado por um germe letal e misterioso, descoberto há pouco tempo. Os médicos rapidamente ordenaram que ele fosse colocado em isolamento na unidade de tratamento intensivo.
LEIA TAMBÉM
O germe, o fungo Candida auris, descoberto recentemente, ataca pessoas com o sistema imunológico enfraquecido, e está se espalhando silenciosamente por todo o planeta. Nos últimos cinco anos, atingiu uma unidade neonatal na Venezuela, varreu um hospital na Espanha, forçou um prestigioso centro médico britânico a suspender as operações de sua unidade de terapia intensiva e fincou raízes na Índia, Paquistão e África do Sul.
Recentemente, o Candida auris chegou a Nova York, Nova Jersey e a Illinois, o que levou os Centros de Controle e Prevenção de Doenças (CDC) dos Estados Unidos a inclui-lo em uma lista de germes classificados como "ameaças urgentes".
O paciente do Mount Sinai morreu depois de 90 dias no hospital, mas o Candida auris não foi contido. Exames mostraram que o fungo estava presente em todo o quarto do paciente, a ponto de o hospital necessitar de equipamento especial de limpeza; também foi necessário arrancar algumas das placas do teto e das lajotas do piso para erradicá-lo.
"Tudo mostrava sinais de presença —as paredes, a cama, as portas, cortinas, telefones, a pia, o quadro branco, os suportes de soro, a bomba", disse Scott Lorin, o presidente do Mount Sinai. "O colchão, as grades da cama, os buracos para encaixe, as persianas, o teto —tudo que existia no quarto mostrava sinais de presença do germe".
O Candida auris é tenaz a esse ponto em parte porque resiste aos principais medicamentos antifúngicos, o que faz dele um novo exemplo de uma das ameaças mais intratáveis à saúde do planeta: as infecções resistentes a medicamentos.
Os especialistas em saúde pública vêm alertando há décadas que o uso exagerado de antibióticos estava reduzindo a efetividade dos remédios que estenderam expectativas de vida ao curar infecções bacterianas que no passado eram causas de morte.
Mas, recentemente, também surgiu uma explosão de fungos resistentes a medicação, o que acrescenta uma dimensão nova e assustadora a um fenômeno que está solapando um dos pilares da medicina moderna.
"É um problema enorme", disse Matthew Fisher, professor de epidemiologia fúngica no Imperial College London e coautor de uma revisão científica recente sobre os fungos resistentes a medicamentos. "Confiamos em medicamentos antifúngicos para tratar esses pacientes".
Em resumo, os fungos, como as bactérias, estão desenvolvendo defesas para sobreviver aos medicamentos modernos.
Mas apesar de os líderes mundiais de saúde virem apelando por uso mais contido de medicamentos antibióticos no combate a fungos e bactérias —inclusive à Assembleia Geral da ONU, em 2016, para que ela ajudasse a administrar a crise emergente—, o uso exagerado desses remédios por hospitais e clínicas e na agricultura continua.
Os germes resistentes costumam ser chamados de "superbugs" [superpragas], mas isso é simplista porque eles não matam todo mundo, tipicamente. Em lugar disso, são mais letais para pessoas com sistemas imunológicos imaturos ou comprometidos, entre as quais recém-nascidos e idosos, fumantes, diabéticos e pessoas com distúrbios do sistema imunológico e que usam anabolizantes que reduzam as defesas do corpo.
Os cientistas dizem que a menos que novos medicamentos, mais efetivos, sejam desenvolvidos e que o uso desnecessário de antibióticos seja restringido severamente, o risco se expandirá para populações maiores. Um estudo bancado pelo governo britânico projeta que, se não forem adotadas medidas que contenham a ascensão da resistência a medicamentos, 10 milhões de pessoas podem morrer como resultado dessas infecções em 2050, o que eclipsará as oito milhões de mortes causadas por câncer previstas para aquele ano.
Nos Estados Unidos, dois milhões de pessoas contraem infecções resistentes a tratamento a cada ano, e 23 mil delas morrem por isso, de acordo uma estimativa oficial do CDC. O número se baseia em dados de 2010; estimativas mais recentes, pela escola de medicina da Universidade de Washington, estimam as mortes em 162 mil. No mundo, a estimativa é de que 700 mil pessoas morram a cada ano de infecções resistentes a tratamento.
Os antibióticos e os antifúngicos são essenciais para combater infecções em humanos, mas os antibióticos também são usados amplamente para prevenir doenças em rebanhos, e antifúngicos são usados para impedir que plantas apodreçam. Alguns cientistas mencionam indicadores de que o uso exagerado de fungicidas em safras agrícolas está contribuindo para a ascensão de fungos resistentes a drogas e que infectam pessoas.
No entanto, o problema cada vez mais grave continua a não ser compreendido pelo público —em parte porque as infecções resistentes a remédios muitas vezes terminam envoltas em segredo.
Tanto no caso das bactérias quanto no dos fungos, os hospitais e os governos relutam em divulgar surtos por medo de que os locais passem a ser vistos como focos de infecção. Mesmo o CDC, nos termos de seu acordo com os governos estaduais americanos, está proibido de divulgar locais e nomes de hospitais envolvidos em surtos. Governos estaduais decidem, em muitos casos, não publicar informações sobre o assunto, limitando-se a admitir que houve casos.
Enquanto isso, os germes se espalham com facilidade —carregados nas mãos dos profissionais de saúde e equipamentos hospitalares; transportados na carne para consumo e nos vegetais produzidos com estrume nas fazendas; conduzido a outros países por viajantes e em produtos de importação e exportação; e transferidos por pacientes de casas de repouso para hospitais, e vice-versa.
LEIA MAIS
+Lidas